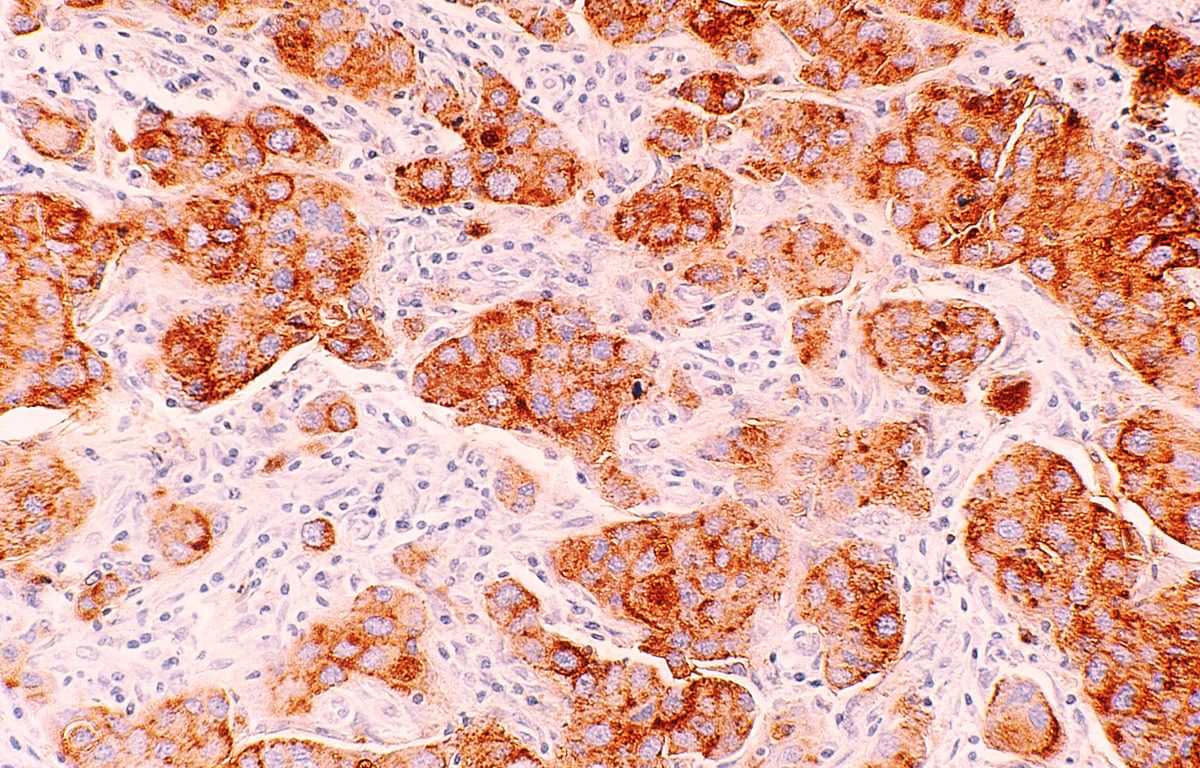

Simran Kaur ‘20
Complete surgical resection of breast tissue, known as a mastectomy, is often suggested as the first-line treatment in patients diagnosed with breast cancer. Metastasis, the spread of cancer cells to other parts of the body, is a frequent occurrence after surgery and is the primary cause of cancer-related deaths. It was hypothesized by the researchers in this study that the type of anesthetics used during resection surgery affects lung metastasis in Syngeneic 4T1 and xenograft MDA-MB-231 breast cancer mice models.
Previous studies have suggested adverse reactions to more volatile types of anesthetics, which includes sevoflurane. Syngeneic 4T1 and xenograft human breast MDA-MB-231 mouse models, that mimic the morphology of human breast cancer were used in the experiment. 4T1 mouse cells exhibit highly tumorigenic behavior and metastasize to other organs. MDA-MB-231 cells are a highly aggressive epithelial breast cancer line, that can metastasize to the blood, brain, and lungs.
When tumor volumes reached 500mm3, researchers anesthetized the mice for complete mastectomy; approximately three hours of sedation. Half of each group of mice received propofol through intravenous administration, the less severe anesthetic, and the other half received the volatile anesthetic sevoflurane through inhalation. Two weeks following resection, the mice that were administered the strong anesthetic developed a greater amount of lung metastases in comparison to the group that received a weaker anesthetic. Histology performed on pulmonary samples indicated larger and more abundant nodules in the sevoflurane group. Researchers identified interleukin 6 (IL-6), a pro-inflammatory cytokine, as the lung metastatic contributor activated by sevoflurane. The researchers also administered anesthesia in vivo without performing surgery, and discovered that sevoflurane only exhibits detrimental metastatic effects following resection surgery. The findings of this study indicate the significance of anesthetics in cancer metastasis after resection surgery, and questions the safety of sevoflurane, a commonly used anesthetic, in diagnosed cancer patients. Further studies, however, are necessary to establish the findings of this experiment, and to determine the potential of an IL-6 inhibitor for the alleviation of metastasis caused by sevoflurane.
References:
- R. Li, Y. Huang, & J. Lin, Distinct Effects of General Anesthetics on Lung Metastasis Mediated by IL-6/JAK/STAT3 Pathway in Mouse Models. Nature Communications, (2020). Doi: 10.1038/s41467-019-14065-6
- Image retrieved from: https://commons.wikimedia.org/wiki/File:Breast_cancer_(ductal_carcinoma)_(1).jpg

